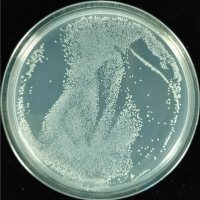
产品图

武汉锐志魔方生物科技有限公司免费会员
公司介绍
武汉锐志魔方生物科技有限公司是一家从事科研服务的企业,坐落于国家级生物产业基地光谷生物城生物创新园,拥有微生物基因编辑、微生物检测、文库构建筛选、分子检测/互作等4大平台。锐志魔方生物自主研发的 cubes-seq技术,替代常规的重测序技术快速寻找到外源片段(如转座子)在基因组中的插入位置,可极大提高转座子突变体文库的鉴定效率,并降低实验成本。
公司凭借多年来累积的微生物培养转化经验和强大的分子生物学背景,全力发展微生物基因编辑技术,立志成为国内微生物基因编辑领域的标杆企业,目前已在十多种细菌及真菌中建立CRISPR基因编辑体系,完成基因编辑项目超过30项。
公司奉行诚信为本、科学严谨、创新争先的企业文化,我们立志于服务好每一位信任并选择锐志魔方的客户,为客户提供有价值的产品和服务而不懈努力。
供应产品
详细信息
| 公司名称 | 武汉锐志魔方生物科技有限公司 | 企业类型 | 民营 |
| 经营模式 | 企业地区 | 湖北-武汉市-洪山区 | |
| 经营地址 | 湖北武汉光谷生物城C6栋 | 主要产品 | 细菌转座子突变体库构建和鉴定服务,以及标准株突变体现货库 |
| 公司成立时间 | 2018 | 公司网址 |
免责声明:以上所展示的信息由企业自行提供,内容的真实性、准确性和合法性由发布企业负责,丁香园对此不承担任何保证责任。